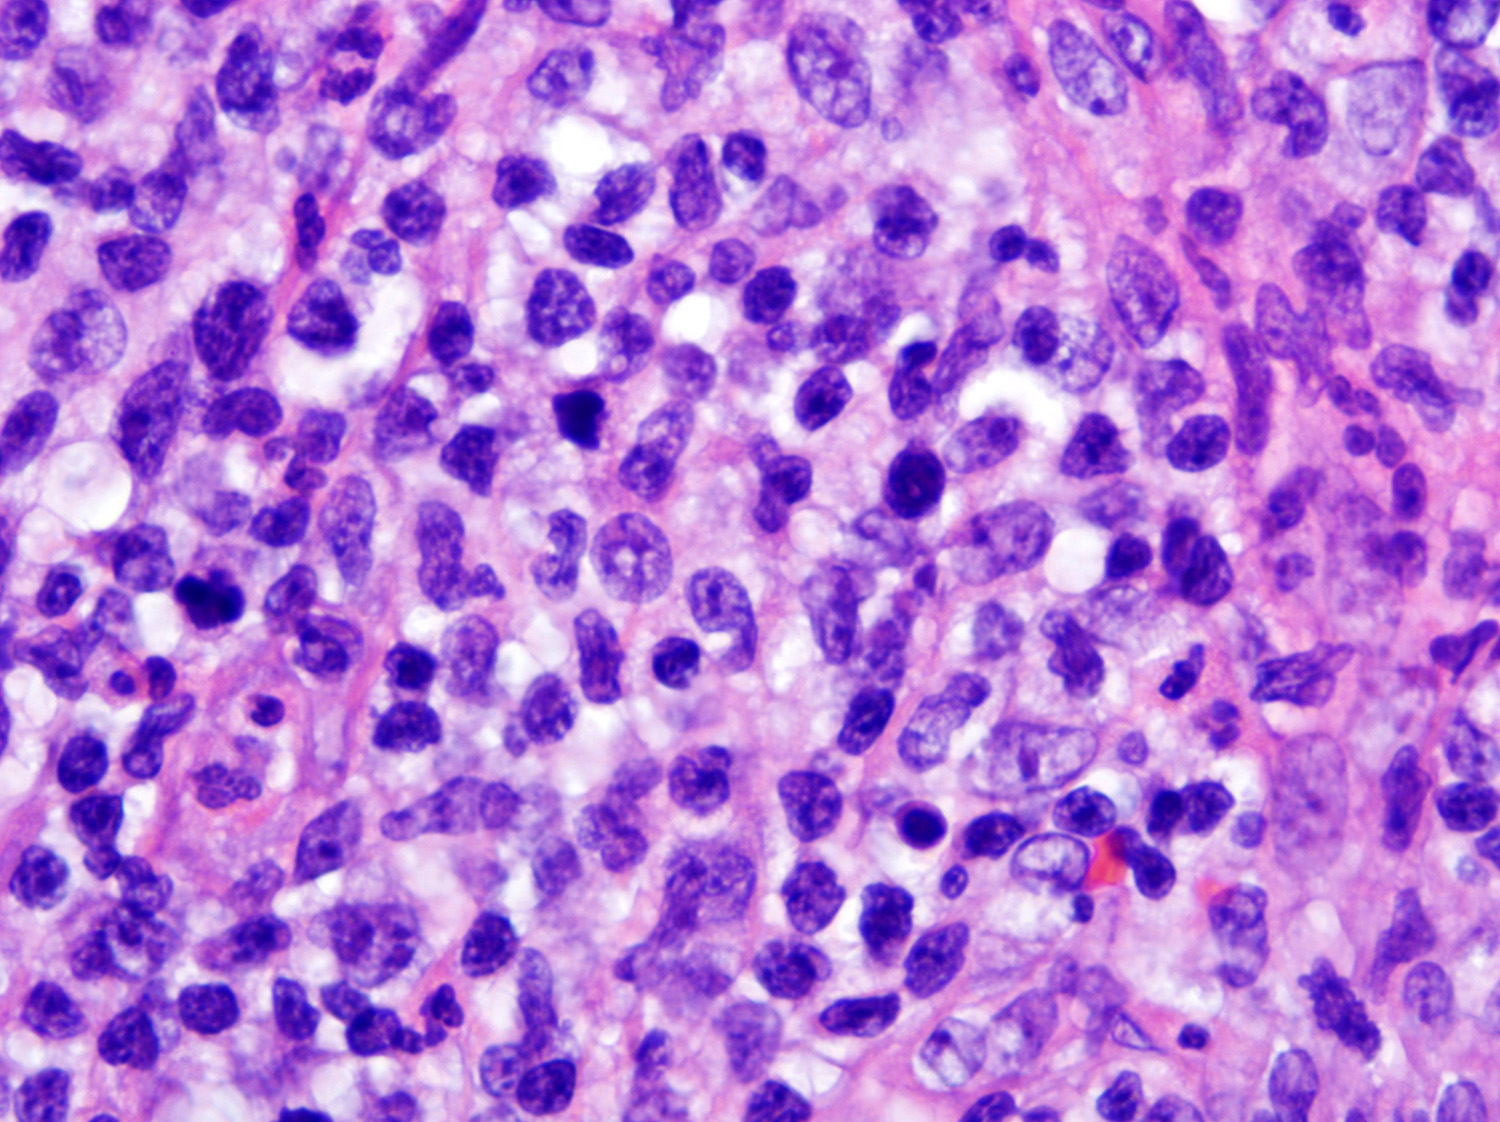

新入荷
再入荷
Diagnostic Pathology: Lymph Nodes and Extranodal Lymphomas
 タイムセール
タイムセール
終了まで
00
00
00
999円以上お買上げで送料無料(※)
999円以上お買上げで代引き手数料無料
999円以上お買上げで代引き手数料無料
通販と店舗では販売価格や税表示が異なる場合がございます。また店頭ではすでに品切れの場合もございます。予めご了承ください。
商品詳細情報
| 管理番号 |
新品 :99918141760
中古 :99918141760-1 |
メーカー | 2108e600324fa3 | 発売日 | 2025-04-14 01:10 | 定価 | 21735円 | ||
|---|---|---|---|---|---|---|---|---|---|
| カテゴリ | |||||||||
Diagnostic Pathology: Lymph Nodes and Extranodal Lymphomas
 Diagnostic Pathology: Lymph Nodes and Extranodal Lymphomas,
Diagnostic Pathology: Lymph Nodes and Extranodal Lymphomas, Frontiers | Thymic Extranodal Marginal-Zone Lymphoma of,
Frontiers | Thymic Extranodal Marginal-Zone Lymphoma of, Pathology Outlines - Extranodal NK / T cell lymphoma,
Pathology Outlines - Extranodal NK / T cell lymphoma, Pathology Outlines - Extranodal NK / T cell lymphoma
Pathology Outlines - Extranodal NK / T cell lymphoma


















![橋本クロス 橋本 モーターフィルター 粘着タイプ(薄手)150ΦMM 厚さ2mm NUM150 [1216-1750275]](https://tshop.r10s.jp/daishinshop/cabinet/item/1216-1/1216-1750275.jpg)








